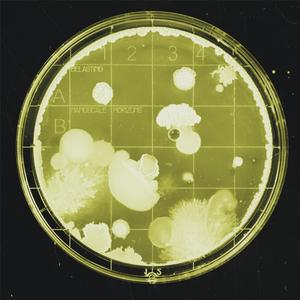
Bystander Effect

Nanoscale (Original Mix)
Tuxedo

Nanoscale
Geordie Haley

Nanoscale
Martin Schioeler

Nanoscale
Wesal Scar

Nanoscale
Burg

Nanoscale
Tuxedo

Nanoscale
Various Artists

Nanoscale Dual Polarized
Kevin Ferguson

Nano-scale Apocalypse
ApolloSonics

I HATE MONDAY
BOB MORIGASAKI, B政, nano scale hate

Nanoscales
theologists

Bystander Effect
belasting

Stable
belasting

Cellular Senescence
belasting

Immunoassay
belasting

Molecular Hijacking
belasting

MODS
belasting

Vacuum State
belasting

Degeneration
belasting

Contaminant
belasting

Hypoperfusion
belasting
Cessation
belasting

Random Scaler
4O5人

Complex Scale
Martin Schioeler

Nano
Paul Dickenert

Skeleton Scale
Sintax

SMASHING NANOSCALE STRUCTURES
Acid Injector

Economy of Scale
Riesenradler

Evil Temperament Scale
NanoTheory

Escale
Orfilab